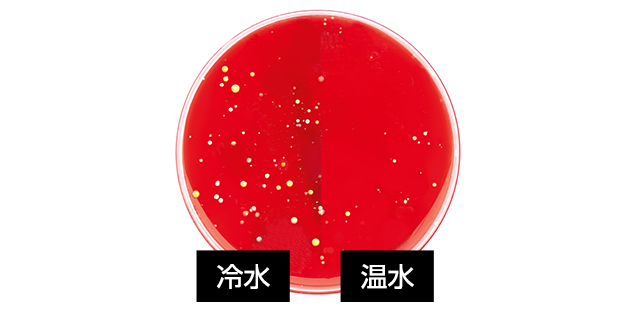
4. 衛生向上

温水なら洗浄時間35%削減
洗浄において熱は重要な要素で、化学反応を促進します。温度が20℃上がると、反応速度は約4倍になります。
ケルヒャーボイラーでは、最大155℃*まで加熱が可能。高温水は油脂や煤などを迅速に分解し、洗浄時間を最大35%短縮します。洗浄後の乾燥もすみやかです。
*機種により異なります。

燃焼効率が高いケルヒャーのボイラー
ケルヒャーの温水高圧洗浄機は、水が通るステンレス製ヒートコイルを直接加熱するため、貯湯式に比べ、燃焼効率が高く、燃費面でも優れています。
短時間で高温水を得られ、安定した高温吐出による高い洗浄力を発揮します。
さらに、スチーム洗浄*も可能です。

温水洗浄のメリット

1. 洗浄力アップ
■温水で油脂やグリースを柔らかく、乳化作用を促進
■食品工場のタンパク質汚れも短時間で分解

2. 洗剤使用量削減
■温水だけで多くの汚れを除去
■洗剤コスト&環境負荷を削減

3. 乾燥時間短縮
■高温で洗浄後の乾燥が早い
■次工程への移行がスムーズ
4. 衛生向上
■バクテリア・ウイルスを減少
■消毒剤なしでも衛生要件をクリア可能
業界別に見る温水高圧洗浄機の利用シーン

建設・土木業

農業

畜産業

物流業

ビルメンテナンス業

食品加工・食品製造業
多様な活用方法

スチーム除菌・衛生対応

環境にやさしい温水除草

融雪
お問い合わせ
お問い合わせ内容と必要事項をご入力ください。
折り返し担当者よりご連絡させていただきます。
お問い合わせの対応につきましては、できる限り迅速に対応をするよう努力いたしますが、お時間をいただく場合があります。
*は必須項目です。








